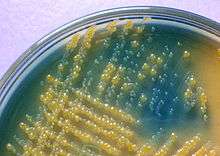

Cystine lactose electrolyte deficient agar

A clear CLED agar plate after cultivation
Colonies of lactose and non-lactose fermenting bacteria on CLED agar
CLED agar (cystine lactose electrolyte deficient medium) is a valuable non-inhibitory growth medium used in the isolation and differentiation of urinary organisms. Being electrolyte deficient, it prevents the swarming of Proteus species. Cystine promotes the formation of cystine-dependent dwarf colonies. Bromothymol blue is the indicator used in the agar, it changes to yellow in case of acid production during fermentation of lactose or changes to deep blue in case of alkalinization. Lactose-positive bacteria build yellow colonies. Bacteria which decarboxylate L-Cystine cause an alkaline reaction and build deep blue colonies[1]
| Peptone | 4g/l |
| 'Lab Lemco' powder | 3g/l |
| Tryptone | 4g/l |
| Lactose | 10g/l |
| L-Cystine | 128 mg/l |
| Bromothymol blue | 20 mg/l |
| Agar No. 1 | 15g/l |
References
- ↑ Analytical, Fluka. "55420 CLED Agar (Cystine-Lactose-Electrolyte Deficient Agar; Bromothymol-blue Lactose Cystine Agar)" (PDF). Fluka Analytical. Retrieved 18 October 2014.
This article is issued from Wikipedia - version of the 11/6/2014. The text is available under the Creative Commons Attribution/Share Alike but additional terms may apply for the media files.